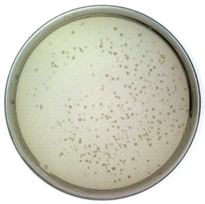
Toxins 14 00683 i001 Toxins 14 00683 i001
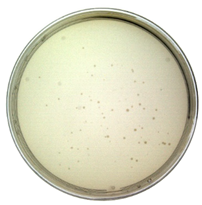
Toxins 14 00683 i002 Toxins 14 00683 i002

Construction, Characterization, and Application of a Nonpathogenic Virus-like Model for SARS-CoV-2 Nucleocapsid Protein by Phage Display
Abstract
1. Introduction
2. Results
2.1. Confirmation of the Constructed Model
2.2. Characterization of the Constructed Model
Titer Determination
2.3. Application for the Constructed Model
2.3.1. Establishment of qPCR Standard Curve
2.3.2. Affinity Analysis
2.3.3. ATR–FTIR Combined PCA-LDA Algorithm to Classify and Identify Substance Bio-Threats Such as Model-N
3. Conclusions
4. Materials and Methods
4.1. Materials and Instruments
4.1.1. Materials
4.1.2. Instruments
4.2. Model-N Construction
4.2.1. Preparation for the Target Gene: PCR Amplification and Double Endonuclease Digestion
4.2.2. Preparation for the Vector: Double Endonuclease Digestion
4.2.3. Construction for the Recombinant Vector
4.2.4. Cultivation and Phage Display
4.3. Model-N Characterization and Verification
4.3.1. Insertion of the Gene Fragments
4.3.2. Western Blotting
4.3.3. ELISA
4.3.4. Titer Determination
4.4. Model-N Application
4.4.1. qPCR Quantification
4.4.2. Affinity Assessment
4.4.3. Classification and Identification of Model-N by ATR–FTIR
Supplementary Materials
Author Contributions
Funding
Institutional Review Board Statement
Informed Consent Statement
Data Availability Statement
Conflicts of Interest
References
- Qin, X.; Li, S.; Li, X.; Pei, D.; Liu, Y.; Ding, Y.; Liu, L.; Bi, H.; Shi, X.; Guo, Y.; et al. Development of an Adeno-Associated Virus-Vectored SARS-CoV-2 Vaccine and Its Immunogenicity in Mice. Front. Cell. Infect. Microbiol. 2022, 12, 802147. [Google Scholar] [CrossRef] [PubMed]
- Zhu, F.-C.; Li, Y.-H.; Guan, X.-H.; Hou, L.-H.; Wang, W.-J.; Li, J.-X.; Wu, S.-P.; Wang, B.-S.; Wang, Z.; Wang, L.; et al. Safety, tolerability, and immunogenicity of a recombinant adenovirus type-5 vectored COVID-19 vaccine: A dose-escalation, open-label, non-randomised, first-in-human trial. Lancet 2020, 395, 1845–1854. [Google Scholar] [CrossRef]
- Chu, K.B.; Kang, H.J.; Yoon, K.W.; Lee, H.A.; Moon, E.K.; Han, B.K.; Quan, F.S. Influenza Virus-like Particle (VLP) Vaccines Expressing the SARS-CoV-2 S Glycoprotein, S1, or S2 Domains. Vaccines 2021, 9, 920. [Google Scholar] [CrossRef] [PubMed]
- Kim, C.; Kim, J.D.; Seo, S.U. Nanoparticle and virus-like particle vaccine approaches against SARS-CoV-2. J. Microbiol. 2022, 60, 335–346. [Google Scholar] [CrossRef] [PubMed]
- Xing, H.; Zhu, L.; Wang, P.; Zhao, G.; Zhou, Z.; Yang, Y.; Zou, H.; Yan, X. Display of receptor-binding domain of SARS-CoV-2 Spike protein variants on the Saccharomyces cerevisiae cell surface. Front. Immunol. 2022, 13, 935573. [Google Scholar] [CrossRef] [PubMed]
- Lotfi, Z.; Golchin, M.; Khalili-Yazdi, A.; Khalili, M. Immunological properties of the SLLTEVET epitope of Influenza A virus in multiple display on filamentous M13 phage. Comp. Immunol. Microbiol. Infect. Dis. 2019, 65, 76–80. [Google Scholar] [CrossRef]
- Wu, D.; Li, G.; Qin, C.; Ren, X. Phage displayed peptides to avian H5N1 virus distinguished the virus from other viruses. PLoS ONE 2011, 6, e23058. [Google Scholar] [CrossRef]
- Zhang, Y.; Song, Y.; Ren, H.; Zeng, Q.; Yuan, Y.; Xia, L.; Wei, Z. Preparation of a Single-Chain Antibody against Nucleocapsid Protein of Porcine Deltacoronavirus by Phage Display Technology. Viruses 2022, 14, 772. [Google Scholar] [CrossRef]
- Jaroszewicz, W.; Morcinek-Orlowska, J.; Pierzynowska, K.; Gaffke, L.; Wegrzyn, G. Phage display and other peptide display technologies. FEMS Microbiol. Rev. 2022, 46, fuab052. [Google Scholar] [CrossRef]
- Flego, M.; Di Bonito, P.; Ascione, A.; Zamboni, S.; Carattoli, A.; Grasso, F.; Cassone, A.; Cianfriglia, M. Generation of human antibody fragments recognizing distinct epitopes of the nucleocapsid (N) SARS-CoV protein using a phage display approach. BMC Infect. Dis. 2005, 5, 73. [Google Scholar] [CrossRef]
- Petrenko, V.A.; Gillespie, J.W.; De Plano, L.M.; Shokhen, M.A. Phage-Displayed Mimotopes of SARS-CoV-2 Spike Protein Targeted to Authentic and Alternative Cellular Receptors. Viruses 2022, 14, 384. [Google Scholar] [CrossRef] [PubMed]
- Yang, F.; Liu, L.; Neuenschwander, P.F.; Idell, S.; Vankayalapati, R.; Jain, K.G.; Du, K.; Ji, H.; Yi, G. Phage Display-Derived Peptide for the Specific Binding of SARS-CoV-2. ACS Omega 2022, 7, 3203–3211. [Google Scholar] [CrossRef] [PubMed]
- Somasundaram, R.; Choraria, A.; Antonysamy, M. An approach towards development of monoclonal IgY antibodies against SARS CoV-2 spike protein (S) using phage display method: A review. Int. Immunopharmacol. 2020, 85, 106654. [Google Scholar] [CrossRef] [PubMed]
- Bruisson, S.; Lebel, S.; Walter, B.; Prevotat, L.; Seddas, S.; Schellenbaum, P. Comparative detection of a large population of grapevine viruses by TaqMan((R)) RT-qPCR and ELISA. J. Virol. Methods 2017, 240, 73–77. [Google Scholar] [CrossRef] [PubMed]
- Chen, L.; Ruan, F.; Sun, Y.; Chen, H.; Liu, M.; Zhou, J.; Qin, K. Establishment of sandwich ELISA for detecting the H7 subtype influenza A virus. J. Med. Virol. 2019, 91, 1168–1171. [Google Scholar] [CrossRef] [PubMed]
- de Oliveira Lopes, G.A.; Ferreira, L.R.; de Souza Trindade, G.; Fonseca, A.A., Jr.; Dos Reis, J.K.P. qPCR assay for the detection of pseudocowpox virus. Arch. Virol. 2021, 166, 243–247. [Google Scholar] [CrossRef]
- Irshad, M.; Gupta, P.; Mankotia, D.S.; Ansari, M.A. Multiplex qPCR for serodetection and serotyping of hepatitis viruses: A brief review. World J. Gastroenterol. 2016, 22, 4824–4834. [Google Scholar] [CrossRef]
- Salman, A.; Shufan, E.; Zeiri, L.; Huleihel, M. Characterization and detection of Vero cells infected with Herpes Simplex Virus type 1 using Raman spectroscopy and advanced statistical methods. Methods 2014, 68, 364–370. [Google Scholar] [CrossRef]
- Rehman, A.; Anwar, S.; Firdous, S.; Ahmed, M.; Rasheed, R.; Nawaz, M. Dengue blood analysis by Raman spectroscopy. Laser Phys. 2012, 22, 1085–1089. [Google Scholar] [CrossRef]
- Desai, S.; Mishra, S.V.; Joshi, A.; Sarkar, D.; Hole, A.; Mishra, R.; Dutt, S.; Chilakapati, M.K.; Gupta, S.; Dutt, A. Raman spectroscopy-based detection of RNA viruses in saliva: A preliminary report. J. Biophotonics 2020, 13, e202000189. [Google Scholar] [CrossRef]
- Barauna, V.G.; Singh, M.N.; Barbosa, L.L.; Marcarini, W.D.; Vassallo, P.F.; Mill, J.G.; Ribeiro-Rodrigues, R.; Campos, L.C.G.; Warnke, P.H.; Martin, F.L. Ultrarapid On-Site Detection of SARS-CoV-2 Infection Using Simple ATR-FTIR Spectroscopy and an Analysis Algorithm: High Sensitivity and Specificity. Anal. Chem. 2021, 93, 2950–2958. [Google Scholar] [CrossRef] [PubMed]
- Hansen, L.; De Beer, T.; Pierre, K.; Pastoret, S.; Bonnegarde-Bernard, A.; Daoussi, R.; Vervaet, C.; Remon, J.P. FTIR spectroscopy for the detection and evaluation of live attenuated viruses in freeze dried vaccine formulations. Biotechnol. Prog. 2015, 31, 1107–1118. [Google Scholar] [CrossRef] [PubMed]
- Pizarro, C.; Esteban-Diez, I.; Arenzana-Ramila, I.; Gonzalez-Saiz, J.M. Discrimination of patients with different serological evolution of HIV and co-infection with HCV using metabolic fingerprinting based on Fourier transform infrared. J. Biophotonics 2018, 11, e201700035. [Google Scholar] [CrossRef]
- Santos, M.C.D.; Nascimento, Y.M.; Araújo, J.M.G.; Lima, K.M.G. ATR-FTIR spectroscopy coupled with multivariate analysis techniques for the identification of DENV-3 in different concentrations in blood and serum: A new approach. RSC Adv. 2017, 7, 25640–25649. [Google Scholar] [CrossRef]
- Sitole, L.; Steffens, F.; Kruger, T.P.; Meyer, D. Mid-ATR-FTIR spectroscopic profiling of HIV/AIDS sera for novel systems diagnostics in global health. Omics 2014, 18, 513–523. [Google Scholar] [CrossRef] [PubMed]
- Fang, M.; Diao, W.; Dong, B.; Wei, H.; Liu, J.; Hua, L.; Zhang, M.; Guo, S.; Xiao, Y.; Yu, Y.; et al. Detection of the Assembly and Disassembly of PCV2b Virus-Like Particles Using Fluorescence Spectroscopy Analysis. Intervirology 2015, 58, 318–323. [Google Scholar] [CrossRef]
- Peng, J.; Song, K.; Zhu, H.; Kong, W.; Liu, F.; Shen, T.; He, Y. Fast detection of tobacco mosaic virus infected tobacco using laser-induced breakdown spectroscopy. Sci. Rep. 2017, 7, 44551. [Google Scholar] [CrossRef]
- Rudt, M.; Vormittag, P.; Hillebrandt, N.; Hubbuch, J. Process monitoring of virus-like particle reassembly by diafiltration with UV/Vis spectroscopy and light scattering. Biotechnol. Bioeng. 2019, 116, 1366–1379. [Google Scholar] [CrossRef]
- Moon, J.S.; Choi, E.J.; Jeong, N.N.; Sohn, J.R.; Han, D.W.; Oh, J.W. Research Progress of M13 Bacteriophage-Based Biosensors. Nanomaterials 2019, 9, 1448. [Google Scholar] [CrossRef]
- Chung, W.J.; Lee, D.Y.; Yoo, S.Y. Chemical modulation of M13 bacteriophage and its functional opportunities for nanomedicine. Int. J. Nanomed. 2014, 9, 5825–5836. [Google Scholar] [CrossRef]
- Ledsgaard, L.; Kilstrup, M.; Karatt-Vellatt, A.; McCafferty, J.; Laustsen, A.H. Basics of Antibody Phage Display Technology. Toxins 2018, 10, 236. [Google Scholar] [CrossRef] [PubMed]
- Gao, T.; Gao, Y.; Liu, X.; Nie, Z.; Sun, H.; Lin, K.; Peng, H.; Wang, S. Identification and functional analysis of the SARS-COV-2 nucleocapsid protein. BMC Microbiol. 2021, 21, 58. [Google Scholar] [CrossRef] [PubMed]
- Ye, Q.; West, A.M.V.; Silletti, S.; Corbett, K.D. Architecture and self-assembly of the SARS-CoV-2 nucleocapsid protein. Protein Sci. 2020, 29, 1890–1901. [Google Scholar] [CrossRef] [PubMed]
- Zeng, W.; Liu, G.; Ma, H.; Zhao, D.; Yang, Y.; Liu, M.; Mohammed, A.; Zhao, C.; Yang, Y.; Xie, J.; et al. Biochemical characterization of SARS-CoV-2 nucleocapsid protein. Biochem. Biophys. Res. Commun. 2020, 527, 618–623. [Google Scholar] [CrossRef] [PubMed]
- Yang, D.; Singh, A.; Wu, H.; Kroe-Barrett, R. Dataset of the binding kinetic rate constants of anti-PCSK9 antibodies obtained using the Biacore T100, ProteOn XPR36, Octet RED384, and IBIS MX96 biosensor platforms. Data Brief 2016, 8, 1173–1183. [Google Scholar] [CrossRef] [PubMed]
- Yu, Y.; Mitchell, S.; Lynaugh, H.; Brown, M.; Nobrega, R.P.; Zhi, X.; Sun, T.; Caffry, I.; Cao, Y.; Yang, R.; et al. Understanding ForteBio’s Sensors for High-Throughput Kinetic and Epitope Screening for Purified Antibodies and Yeast Culture Supernatant. J. Biomol. Screen. 2016, 21, 88–95. [Google Scholar] [CrossRef]
- Petersen, R.L. Strategies Using Bio-Layer Interferometry Biosensor Technology for Vaccine Research and Development. Biosensors 2017, 7, 49. [Google Scholar] [CrossRef]
- Wallner, J.; Lhota, G.; Jeschek, D.; Mader, A.; Vorauer-Uhl, K. Application of Bio-Layer Interferometry for the analysis of protein/liposome interactions. J. Pharm. Biomed. Anal. 2013, 72, 150–154. [Google Scholar] [CrossRef]








![]() | ![]() | ![]() |
| Dilution ratio: 105 | Dilution ratio: 106 | Dilution ratio: 107 |
| The number of plaques: uncountable | The number of plaques: 70 | The number of plaques: 9 |
| Titer: 1.60 × 109 pfu/mL | ||
| Principal Component | Initial Eigenvalues | |
|---|---|---|
| Percentage of Variance/% | Cumulative Percentage/% | |
| 1 | 50.306 | 50.306 |
| 2 | 18.902 | 69.208 |
| 3 | 15.012 | 84.220 |
| 4 | 10.114 | 94.334 |
| 5 | 2.372 | 96.706 |
| 6 | 1.147 | 97.853 |
| (a) SfiI Digestion System | |
|---|---|
| Target gene (after PCR) | 20 μL |
| 10× buffer1 | 8 μL |
| SfiI enzyme | 4 μL |
| Nuclease-free water | 43 μL |
| Total volume | 75 μL |
| Condition: Incubate at 50 °C for 4 h | |
| (b) NotI digestion system | |
| System after SfiI digestion | 75 μL |
| 10× buffer2 | 10 μL |
| NotI enzyme | 4 μL |
| Nuclease-free water | 11 μL |
| Total volume | 100 μL |
| Condition: Incubate at 37 °C for 4 h | |
| Construction System for pHB-N | |
|---|---|
| Prepared-N-gene | 10 μL |
| Prepared-pHB | 3 μL |
| 10× buffer | 5 μL |
| T4 DNA Ligase | 2 μL |
| Total volume | 20 μL |
| Condition: Incubate at 16 °C overnight | |
| qPCR Reaction | |
|---|---|
| Plasmid | 2 μL |
| Buffer | 10 μL |
| Primer-F | 0.32 μL |
| Primer-R | 0.32 μL |
| Taqman (VIC) | 2 μL |
| Enzyme 2 | 0.4 μL |
| Enzyme 3 | 0.4 μL |
| Nuclease-free water | 4.56 μL |
| Total volume | 20 μL |
Publisher’s Note: MDPI stays neutral with regard to jurisdictional claims in published maps and institutional affiliations. |
© 2022 by the authors. Licensee MDPI, Basel, Switzerland. This article is an open access article distributed under the terms and conditions of the Creative Commons Attribution (CC BY) license (https://creativecommons.org/licenses/by/4.0/).
Share and Cite
Wu, Y.; Liu, B.; Liu, Z.; Zhang, P.; Mu, X.; Tong, Z. Construction, Characterization, and Application of a Nonpathogenic Virus-like Model for SARS-CoV-2 Nucleocapsid Protein by Phage Display. Toxins 2022, 14, 683. https://doi.org/10.3390/toxins14100683
Wu Y, Liu B, Liu Z, Zhang P, Mu X, Tong Z. Construction, Characterization, and Application of a Nonpathogenic Virus-like Model for SARS-CoV-2 Nucleocapsid Protein by Phage Display. Toxins. 2022; 14(10):683. https://doi.org/10.3390/toxins14100683
Chicago/Turabian StyleWu, Yuting, Bing Liu, Zhiwei Liu, Pengjie Zhang, Xihui Mu, and Zhaoyang Tong. 2022. "Construction, Characterization, and Application of a Nonpathogenic Virus-like Model for SARS-CoV-2 Nucleocapsid Protein by Phage Display" Toxins 14, no. 10: 683. https://doi.org/10.3390/toxins14100683
APA StyleWu, Y., Liu, B., Liu, Z., Zhang, P., Mu, X., & Tong, Z. (2022). Construction, Characterization, and Application of a Nonpathogenic Virus-like Model for SARS-CoV-2 Nucleocapsid Protein by Phage Display. Toxins, 14(10), 683. https://doi.org/10.3390/toxins14100683